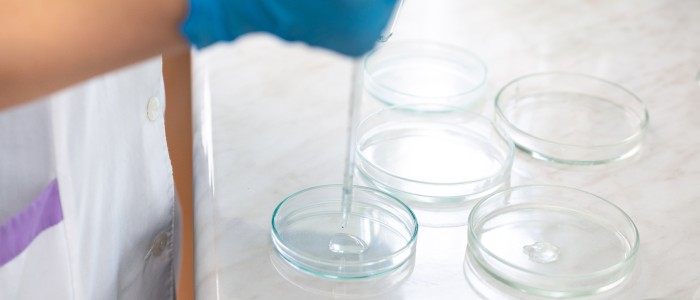
Вчені створили синтетичні людські ембріони, не використовуючи сперму чи яйцеклітину

Вчені створили синтетичні людські ембріони, не використовуючи сперму чи яйцеклітину
Група вчених створила штучні людські ембріони зі стовбурових клітин без використання яйцеклітин та сперматозоїдів — видатний прорив, який порушує безліч складних етичних питань.
Хоча ці ембріони лише нагадують ембріони на ранніх стадіях розвитку — вони ще далекі від формування мозку або серця, що б'ється, — дослідники сподіваються вивчити, як генетичні порушення впливають на цей процес, а також причини повторюваних викиднів.
Проте дослідження має серйозні етичні та юридичні наслідки, повідомляє The Guardian, і в цей час імплантація синтетичних ембріонів у матку пацієнта є незаконною.
Дослідники не планують вирощувати ці ембріони довше узгодженого на міжнародному рівні обмеження в 14 днів, і досі неясно, чи зможуть вони взагалі дозріти після цієї стадії.
Керівник групи Магдалена Зерницька-Гетц, професор біологічної інженерії Кембридзького університету, повідомила CNN, що дослідження вже опубліковано в авторитетному науковому журналі.
Але він ще не опублікований, а це означає, що багато експертів чекають, перш ніж прокоментувати його.
Клітини були вирощені з ембріональних стовбурових клітин людини та оброблені для розвитку клітин, які зазвичай призводять до утворення жовткового мішка, плаценти та самого ембріона.
"Наша людська модель є першою моделлю людського ембріона з трьома лініями, в якій вказані амніонні та зародкові клітини, клітини-попередники яйцеклітин та сперматозоїдів", — розповіла Зерницька-Гетц The Guardian. "Він прекрасний і повністю створений з ембріональних стовбурових клітин."
З огляду на надзвичайно делікатний характер дослідження, Зерницька-Гетц була стримана у своїх заявах для ЗМІ, але все ж наголошувала на важливості своєї роботи.
«Я просто хочу наголосити, що це не людські ембріони», — сказала вона CNN. «Це моделі ембріонів, але вони дуже цікаві, тому що вони дуже схожі на людські ембріони, і це дуже важливий шлях до відкриття того, чому так багато невдалих вагітностей, оскільки більшість вагітностей зазнають невдачі під час розвитку, на якому ми будуємо. ці ембріоноподібні структури."
Зерницька-Гетц та її команда раніше показали, що стовбурові клітини мишей можна змусити збиратися в ранні ембріоноподібні структури, включаючи зачатки мозку і серце, що б'ється.
На той час експерти назвали це "новою технологічною революцією", порівнявши дослідження з "народженням овечки Доллі".
І останні зусилля її команди — це лише початок втілення цієї концепції у людські моделі. Залишається ще багато проблем, і навіть у випадку з мишами ці синтетичні ембріони ще мають успішно виростити в живих тваринах усередині матки.
Навіть синтетичні ембріони мавп, що були імплантовані самкам мавп у Китаї, не прожили й двох днів вагітності.
Крім того, виникає питання щодо регулювання досліджень людських ембріонів. Деякі експерти стверджують, що ці синтетичні моделі ембріонів не повинні підкорятися тим самим законам, що й справжні людські ембріони, але на пошук консенсусу з цього питання може піти деякий час.
"Ці результати свідчать про те, що незабаром ми розробимо технологію вирощування цих клітин за межами 14-денного терміну, що потенційно дозволить отримати більше інформації про розвиток людини", — каже Бі-Бі-Сі Ільдем Акерман, дослідник регуляції генів з Бірмінгемського університету.
"Проте здатність щось робити не виправдовує цього", — додала вона.
Джерела: The Guardian, CNN, BBC



